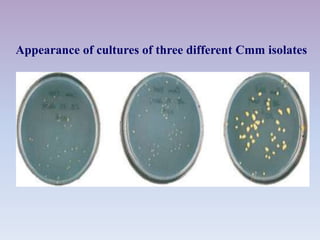
Appearance of cultures of three different Cmm isolates
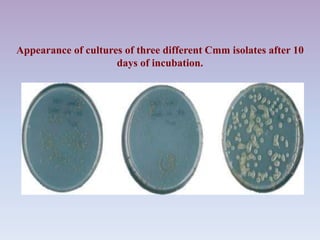
Appearance of cultures of three different Cmm isolates after 10
days of incubation.

The document provides a comprehensive overview of various tomato diseases, including bacterial canker, bacterial spot, bacterial wilt, bacterial speck, early blight, and late blight. Each disease is described with its causal agents, symptoms, conditions for development, and management practices. Effective control strategies such as good sanitation, resistant varieties, crop rotation, and careful irrigation methods are emphasized to mitigate outbreaks.